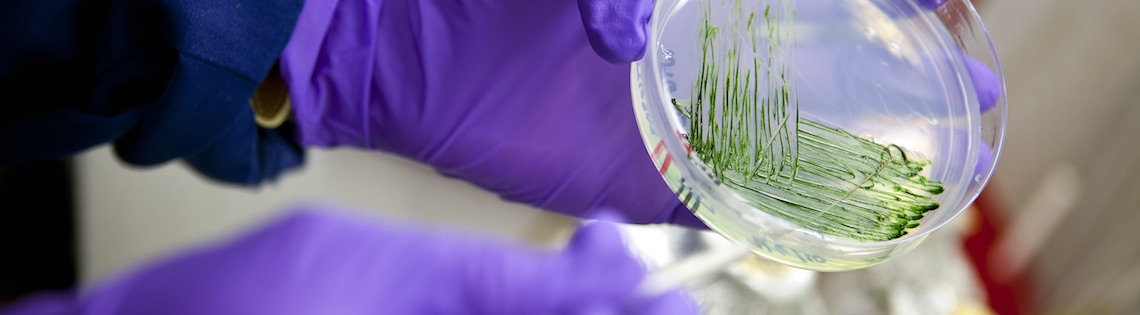

You are scientifically minded and naturally curious about small organisms in our big world.
About Microbiology
In this program, you’ll study the physiology, genetics, ecology, and diversity of microorganisms—like viruses, bacteria, and fungi—and how they impact everything from agriculture to public health and immunology.
Possible Careers
- Clinical laboratory scientist
- Immunologist
- Laboratory research analyst
- Microbiologist
- Quality control analyst
Program Requirements
Once you're an LSU student, you'll need to meet the requirements below to continue pursuing this major.
- 24 credit hours in 1000-level courses or higher
- 2.0 LSU and cumulative GPA
- grade of "C" or better in ENGL 1001
- grade of "C" or better in all math and science courses
- grade of "C" or better in any of the following: Math 1022, Math 1023, Math 1550, or Math 1551
- grade of "C" or better in BIOL 1201, BIOL 1202, CHEM 1201, and MATH 1550
Senior College
Degree
B.S., Bachelor of Science
Course Load by Subject Area
- Science: High Intensity
- Electives: Medium Intensity
- Foreign Language: Medium Intensity
- Lab Hours or Field Work: Medium Intensity
- Math: Medium Intensity
- View all course loads
Related Majors
Tweets by @lsuscience